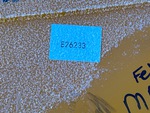

รูปถ่าย 5 รูป
2026 GIYI GY-BK 12 in Excavator Bucket - Fits Cat 307 (Unused)
ตำแหน่งที่ตั้ง
Nisku, AB, CAN
หมายเลขผลิตภัณฑ์
E26233
Loading...
ข้อมูลอุปกรณ์โดยละเอียด
พนักงาน Ritchie Bros. ที่มีคุณสมบัติเหมาะสมได้ทำการรวบรวมข้อมูลโดยละเอียดของอุปกรณ์และทดสอบการใช้งานกับส่วนประกอบหลักของทรัพย์สินนี้แล้ว คุณหรือผู้รับมอบฉันทะอาจตรวจสอบสินค้าใดๆ บนเว็บไซต์ก่อนการประมูลในวันประมูลได้
หมายเลข ID
#14506861
เป็นหลา
ใช่
ปี
2026
ผู้ผลิต
รุ่น
ประเภทสินทรัพย์
หมายเลขผลิตภัณฑ์หรือ VIN
E26233
General Appearance

Picture, Left Front Corner
Picture, Left Rear Corner
Picture, Right Rear Corner
Picture, Right Front Corner
Serial Number / VIN
E26233
ข้อมูลเพิ่มเติม
ข้อกำหนดการประมูลและการขาย
ไม่สามารถถอนการเสนอราคาได้ สินค้าทุกรายการจะขาย ณ “สภาพ และสถานที่” นั้นๆ อ่านข้อกำหนดและเงื่อนไขทั้งหมดก่อนที่จะเสนอราคาข้อกำหนดการประมูลและการขายค่าธรรมเนียมการทำธุรกรรม
ผู้ซื้อที่ซื้อสำเร็จแล้วจะต้องชำระค่าธรรมเนียมการทำธุรกรรมของผู้ซื้อรายละเอียดเพิ่มเติมการชำระเงิน
สินค้าจะต้องชำระเงินเต็มจำนวนภายใน วันศุกร์ที่ 13 กุมภาพันธ์ พ.ศ. 2569 ค่าธรรมเนียมล่าช้า จะถูกนำไปใช้หลังจากวันครบกำหนด
การชำระเงินต้องการข้อมูลเพิ่มเติม
ติดต่อเว็บไซต์กิจกรรมของเราสำหรับข้อมูลเพิ่มเติม(780) 955-2486การจัดส่งและรับของ
- ผู้ซื้อไม่สามารถลบการซื้อของตนออกจากสถานที่ประมูลได้จนกว่าใบแจ้งหนี้จะได้รับการชำระเงินเต็มจำนวน
- ผู้ขับขี่จะต้องนำสำเนาตั๋วรับสินค้าของ Ritchie Bros. Auctioneers มาเพื่อใช้รับสินค้า
- เราได้ร่วมมือกับผู้ให้บริการจัดส่งที่น่าเชื่อถือเพื่ออำนวยความสะดวกคุณในการค้นหาผู้ขนส่งที่ดีที่สุดในราคาประหยัดที่สุด ร้องขอการเสนอราคาฟรีหรือรับการประเมินค่าจัดส่งแบบทันทีจากเว็บไซต์ของผู้ให้บริการของเรา

ตัวประเมินค่าการจัดส่ง
ส่งสินค้าของคุณไปยัง VeriTread แล้วรับใบเสนอราคาค่าขนส่งฟรีแบบไม่มีข้อผูกมัด
ทั่วไป
ข้อมูลอุปกรณ์โดยละเอียดมีขอบเขตจำกัด และผู้จัดประมูลของ Ritchie Bros. ไม่ได้ตรวจสอบลักษณะหรือส่วนประกอบใดๆ ของอุปกรณ์นอกเหนือจากที่ระบุไว้อย่างชัดแจ้งในที่นี้ เว้นแต่จะระบุไว้อย่างชัดแจ้ง เราไม่รับรองหรือรับประกันทั้งโดยชัดแจ้งหรือโดยปริยายเกี่ยวกับอุปกรณ์หรือส่วนประกอบ รวมถึงแต่ไม่จำกัดเพียงการรับรองหรือการรับประกันใดๆ ที่เกี่ยวข้องกับการทำงาน ความสอดคล้องหรือการปฏิบัติตามมาตรฐานความปลอดภัยหรือข้อกำหนดของหน่วยงานที่บังคับใช้หรือหน่วยงานกำกับดูแล ความเหมาะสม เพื่อวัตถุประสงค์เฉพาะใดๆ หรือเพื่อการค้า ขอแนะนำอย่างยิ่งให้ทำการตรวจสอบอุปกรณ์โดยละเอียดด้วยตนเองก่อนการประมูล
การทำงาน
อุปกรณ์ไม่ได้รับการทดสอบภายใต้น้ำหนักบรรทุกหรือใช้งานกับเกียร์ที่มีอยู่ทั้งหมด เราไม่รับรองหรือรับประกันว่าอุปกรณ์จะทำงานตามข้อกำหนดเฉพาะของผู้ผลิต ไม่มีการตรวจสอบใดๆ ที่เกี่ยวข้องกับลักษณะการทำงานใดๆ นอกเหนือจากที่ได้ระบุไว้อย่างชัดแจ้งในที่นี้ มีเพียงภาพถ่ายที่เลือกไว้สำหรับส่วนประกอบช่วงล่างแต่ละชิ้นเท่านั้น และอาจไม่ได้บ่งบอกถึงสภาพของช่วงล่างโดยรวมทั้งหมด
ขนาด
การวัดเป็นเพียงการประมาณการเท่านั้น ขนาดที่บรรทุกจริงอาจแตกต่างกันไปตามความสูงของรถบรรทุก/รถพ่วง และการกำหนดค่า/ตำแหน่งของเครื่องที่บรรทุก เป็นความรับผิดชอบของผู้ซื้อในการวัดน้ำหนักทั้งหมดก่อนออกจากสถานที่ประมูลของเรา เพื่อให้แน่ใจว่าน้ำหนักบรรทุกนั้นปลอดภัยสำหรับการขนส่ง การวัดทั้งหมดควรได้รับการตรวจสอบโดยผู้ซื้อ อย่าพึ่งพาการวัดเหล่านี้เพื่อวัตถุประสงค์ในการขนส่ง




